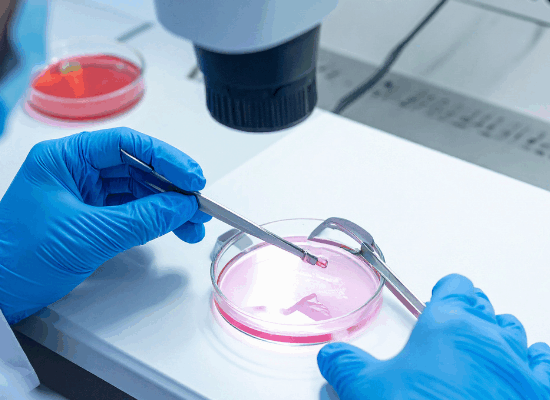

Your Trusted IVF & Fertility Center in Miraj & Sangli
Infertility can be a challenging journey, but with the right medical guidance, many couples successfully conceive. At Somashekhar Hospital, our advanced fertility center in North Karnataka and Western Maharashtra offers comprehensive infertility treatments, specializing in IVF, IUI, and fertility preservation. Our team of leading fertility specialists in Miraj ensures a personalized and compassionate approach to every couple’s parenthood journey.
Why Choose Somashekhar Hospital for Fertility & IVF Treatment?

Highly experienced IVF specialists in Miraj

State-of-the-art embryology lab & fertility diagnostics

Affordable IVF & fertility treatments with high success rates

Comprehensive care for male & female infertility
Fertility Testing & Diagnosis

1. Infertility Workup
A detailed fertility evaluation is the first step towards successful conception. Our infertility specialists in Miraj perform:
- Hormonal assessments to check reproductive health
- Ultrasound scans to assess ovarian and uterine conditions
- Personalized treatment planning based on findings

2. Semen Analysis
Male infertility testing includes:
- Sperm count, motility & morphology analysis
- DNA fragmentation tests for sperm quality
- Tailored treatments for male fertility improvement

3. AMH Testing (Anti-Müllerian Hormone Test)
AMH levels indicate ovarian reserve and egg health. This test helps determine::
- Natural conception potential
- Suitability for IVF & egg freezing
- Personalized fertility treatment plans

4. Scanning & Ultrasound for Fertility
- Follicular monitoring for ovulation tracking
- Early pregnancy scans post-treatment
3D Ultrasonography to detect structural anomalies of uterus
3. AMH Testing (Anti-Müllerian Hormone Test)
AMH levels indicate ovarian reserve and egg health. This test helps determine:
- Natural conception potential
- Suitability for IVF & egg freezing
- Personalized fertility treatment plans
4. Scanning & Ultrasound for Fertility
- Follicular monitoring for ovulation tracking
- Early pregnancy scans post-treatment
3D Ultrasonography to detect structural anomalies of uterus
1. Infertility Workup
A detailed fertility evaluation is the first step towards successful conception. Our infertility specialists in Miraj perform:
- Hormonal assessments to check reproductive health
- Ultrasound scans to assess ovarian and uterine conditions
- Personalized treatment planning based on findings
2. Semen Analysis
Male infertility testing includes:
- Sperm count, motility & morphology analysis
- DNA fragmentation tests for sperm quality
- Tailored treatments for male fertility improvement
Fertility Treatments at Somashekhar Hospital
1. OITI – Ovulation Induction with Timed Intercourse

- Medications to stimulate ovulation
- Precise timing for natural conception
- Ideal for mild fertility concerns
2. IUI – Intrauterine Insemination

- Sperm is processed & placed directly into the uterus
- Enhances conception chances for unexplained infertility
- Non-invasive & cost-effective
IVF – In Vitro Fertilization
Best IVF Treatment in Miraj, Western Maharashtra And North Karnataka
For couples struggling with infertility, IVF (In Vitro Fertilization) offers the highest success rates. At Somashekhar Hospital, our expert IVF specialists in Miraj use cutting-edge reproductive technology to help you conceive.
How Does IVF Work?

- Ovarian Stimulation – Medications to produce multiple eggs
- Egg Retrieval – Eggs are collected from the ovaries
- Sperm Collection & Fertilization – Sperm & eggs are combined in the lab
- Embryo Culture & Selection – The healthiest embryos are chosen
- Embryo Transfer – Selected embryo is transfered into the uterus
- Pregnancy Test – Confirmation after 14 days
Who Needs IVF?

- Couples with blocked fallopian tubes
- Women with low ovarian reserve
- PCOS-related infertility
- Unexplained infertility cases
- Male factor infertility
🔹 Somashekhar Hospital’s IVF center in Miraj & Sangli offers affordable and successful IVF treatment with advanced embryo transfer techniques.
Fertility Preservation Services
Egg & Sperm Freezing

- Ideal for women postponing pregnancy
- Preserves fertility before cancer treatments
- Ensures healthier reproductive options in the future
Embryo Freezing / Vitrification

- Frozen embryos can be used for future IVF cycles
- Higher success rates with vitrification
- Safe and effective storage for long-term use
Start Your Fertility Journey with Somashekhar Fertlity!

Free IVF Consultation
Address : Vijay Colony, Shivaji Nagar, Miraj, Maharashtra 416410
Phone No – 0233 222 4177
Email Id – vctrust1487@gmail.com
OPD Timing
10 AM – 2 PM
4 PM – 6 PM
Quick Links
2025 © Somashekhar Hospital. All Rights Reserved. | Designed & Developed by Social Networth